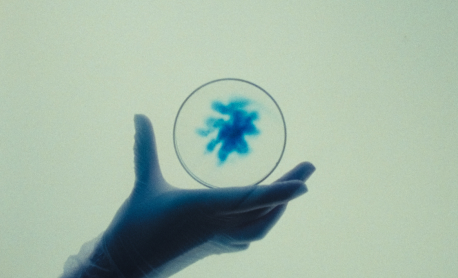
MATHEO DELANNOY

Hi, I’m Matheo Delannoy, an art director and designer based in Paris, working across lifestyle and luxury.
I create identities and visual worlds that extend across mediums, from brand systems and imagery to film, print, and spatial expressions. My approach is concept-driven and attentive to detail, balancing structure with intuition.
I’m interested in projects where strategy and sensibility meet, and where a strong visual language can give a brand presence and longevity. I work across the full trajectory of a project, from positioning to execution, with a focus on clarity, coherence, and craft.










Directed by Massimiliano Bomba, the campaign mirrors this tension through arresting contrasts: extreme close-ups of crystalline jasmine against textures, slow paced sequences reveal the careful artistry of enfleurage and smoky wood extraction. The visual languageu2014elegant yet rawu2014elevates Acqua di Parmau2019s signature and reflects the fragranceu2019s balance of rawness and refinement. Every frame feels intimately tactile.

Creative Direction
Art DirectionSet Design
CGI
Identity Branding
Editorial & Layout Editing
Motion Graphics